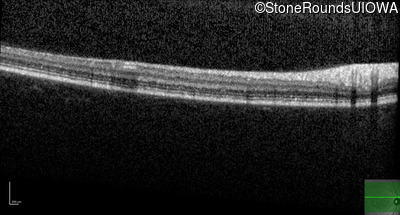
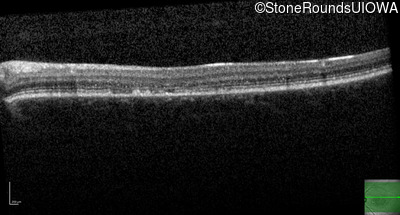
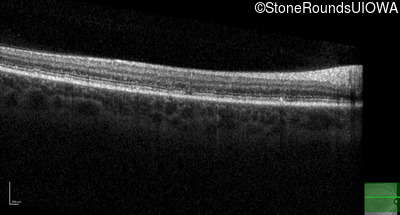
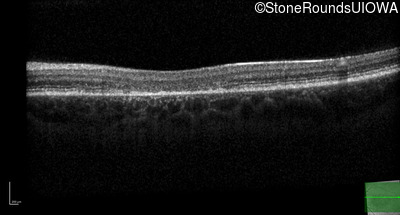
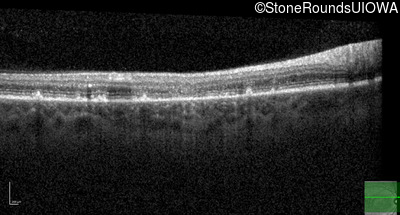
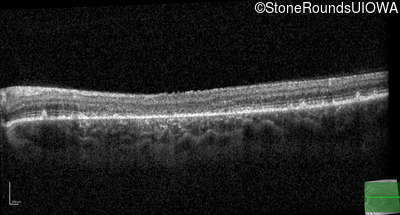

Case
SR1767
Student Mode
AR Stargardt Disease (IIA)
Female
Female
Hidden
SR1767
Student Mode
AR Stargardt Disease (IIA)
Female
Female
History
This 22 year old woman first had difficulty seeing the blackboard at age 14 and this was not correctable with glasses.
| Age at visit: 18 years |
| Age at visit: 19 years |
Diagnosis & molecular findings
| Disease | Gene | Allele 1 variant(s) | Allele 2 variant(s) | Inheritance mode |
|---|---|---|---|---|
| AR Stargardt Disease | ABCA4 | Ala1038Val GCC>GTC | Lys1182 del1aaG | AR |
Disease:
Gene:
Allele 1:
Ala1038Val GCC>GTC
Allele 2:
Lys1182 del1aaG
Inheritance:
AR